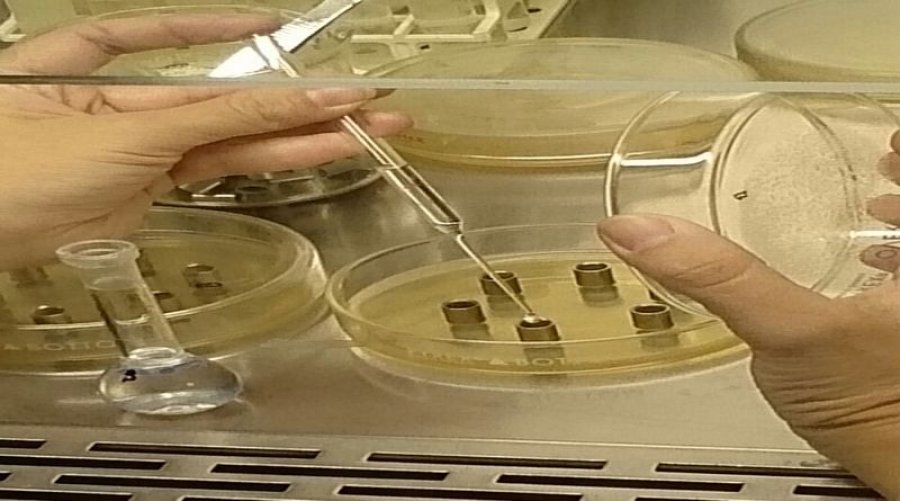

El Ministerio de Salud, a través de la Dirección Registro y Control de Alimentos, recomienda a la población evitar el consumo de una serie de productos por su posible falta de aptitud microbiológica.
La cartera sanitaria explicó que aún no se ha constatado la comercialización de los mismos en nuestra provincia pero como el retiro se está realizando a nivel nacional, se adhiere a la medida preventivamente.
Ante cualquier duda comunicarse con la Dirección Registro y Control de Alimentos – Río Grande Nº 9. Tel. 02901- 423247 o al Departamento Registro y Control de Alimentos Zona Norte - Belgrano N° 316 – Tel. 02964-426370.
Listado de productos
*Choclo entero IQF x 1 kg y 2,5 kg marca: Arganic. Lotes M -17218/1, M -18118/1, M- 17718/8, M -17818/2 con Vto.: 06/10/19. Lotes M- 18318/3, M- 17218/2 con Vto.: 12/10/19.
*Mix Primavera IQF x 2,5 kg marca: Arganic. Lotes: M – 11718/5, M-17218/3 con Vto.: 09/12/18. Lote M-18318/1, Vto.: 17/12/18.
*Mix Primavera especial IQF x 15 kg marca: Arganic. Lote M-17818/1, Vto.: 17/12/18.
*Mix Primavera cortado genérico IQF -1 kg. Lote M 11718/6, con Vto. 09/12/18. Con RNPA N° E/T 4049-28232/17.
*Choclo Supercongelado, marca ARO, 2500 grs, RNPA N° 02-575911, 4089-10454/13 lotes/vto: 163- 17/ 12/06/19,179-17/ 28/06/19 y 312-17/ 08/11/19.
*Choclo Supercongelado, marca DIA 350 grs, RNPA N° 4089-12030/09, lote/vto: 160-17/ 09/06/19,175-17/ 24/06/19,179-17/ 28/06/19, 187-17/ 06/07/19, 159-17/ 16/09/19, 265-17/ 22/09/19, 269-17/ 26/09/19, 272-17/ 29/09/19, 290-17/ 17/10/19, 300-17/ 27/10/19 y 301-17/ 28/10/19.
*Choclo Supercongelado, marca ERIN, 2500 grs, RNPA N° 02-559572, lotes/vto: 163-17/ 12/06/19, 179-17/ 28/06/19, 227-17/ 15/08/19, 268-17/ 25/09/19 y 294-17/ 21/10/19.
*Choclo Supercongelado, marca JUMBO, RNPA N° 02-575911, 300 grs, lote/vto: 205-17/ 24/07/19.
*Choclo Supercongelado, marca LA ANONIMA 300 gr,RNPA N° 02-590262, lotes/vto: 198- 17/17/07/19, 206-17/ 25/07/19, 269-17/ 26/09/19 y 322-17/ 18/11/19.
*Choclo Supercongelado, marca MOLTO, RNPA N° 02-585385, 300 grs, lote/vtos: 235-17/ 25/08/19 y 243-17/ 31/08/19.
*Choclo Supercongelado, marca NELO, 2500 grs, RNPA N° 02-590262, lotes/vto: 163-17/ 12/06/19, RNPA N° 02-576178, lotes/vto: 175-17/ 24/06/19 , 227-17/ 15/10/19, 162-17/ 19/09/19, 312-17/ 08/11/19, 325-17/ 21/11/19 y RNPA N° 02-575911, lote: 179-17/ 28/06/19.
*Choclo Supercongelado, marca, MAGLIA, 300 grs, RNPA N° 02-581452,lotes/vto: 192-17/ 11/07/19, 198-17/ 17/07/19, 259-17/ 16/09/19 y 272-17/ 29/09/19.
*Mix de Vegetales Supercongelado, marca DIA, 400 grs, RNPA N° 4089-10452/13 lotes/vto: 188-17/ 07/07/19, 247-17/ 04/09/19, 292-17/ 19/10/19, 320-17/ 16/11/19.
*Ensalada Ibiza Supercongelada, marca DIA, RNPA N° 4089-12030/09, 350 grs, lotes/vto: 205-17/ 24/07/19, 240-17/ 28/08/19, 266-17/ 23/09/19, 273-17/ 30/09/19 y 290-17/ 17/10/19.
*Mix Primavera Supercongelada, marca CARREFOUR, RNPA N° 2906-17161/14, 300 grs lotes/vto: 280-17/ 07/10/19.
*Mix Primavera Supercongelada, marca DIA, 500 grs, RNPA N° 4089-12030/09, lotes/vto: 184-17/ 03/07/19,192-17/ 11/07/19,200-17/ 19/07/19, 303-17/ 30/10/19, 311-17/ 07/11/19 y 326-17/ 22/11/19.
*Mix Primavera Supercongelada, marca ERIN, 1000 grs, RNPA N° 02-590313, lotes/vto: 184-17/ 03/07/19, 234-17/ 22/08/19 y 326-17/ 22/11/19.
*Mix Primavera Supercongelada, marca ERIN, RNPA N° 02-590313, 2500 grs, lote/vto: 186-17/ 05/07/19.
*Mix Primavera Supercongelada, marca GREAT VALUE, 400 grs, RNPA N° 02-572770, lotes/vto: 264-17/ 21/09/19, 269-17/ 26/09/19, 273-17/ 03/10/19 y 326-17/ 22/11/19.
*Mix Primavera Supercongelada, marca LA ANONIMA, 400 grs, RNPA N°02-570639, lotes/vto: 234- 17/ 22/08/19, 269-17/ 26/09/19, 298-17/ 25/10/19 y 311-17/ 07/11/19.
*Mix Primavera Supercongelada, marca MAGLIA, 400 grs, RNPA N° 2906-12815/17, lotes/vto: 198- 17/ 17/07/19, 200-17/ 19/07/19, 205-17/ 24/07/19, 298-17/ 25/10/19 y 311-17/ 07/11/19.
*Relleno para Tacos con Pollo, marca MAGLIA, RNPA N° 2906-11050/16 400 grs, lote/vto: 212-17/ 31/07/19.
*Relleno para tarta de Vegetales Supercongelados, marca MAGLIA, 400 grs, RNPA N° 02-581375, lotes/vto: 202-17/21/07/19, 282-17/ 09/10/19 y 327-17/ 23/11/19.
*Sopa Supercongelada, marca LA ANONIMA Página 1 de 2, 400 grs, RNPA : 2906-290/15, lote/ Vto: 192-17/11/07/19.
*Wok de Pollo Supercongelado, marca DIA, 400 grs,RNPA: 4089-5282/10, lotes/ vto: 213-17/ 01/08/19, 223-17/ 11/08/19 y 268-17/ 25/09/19.
*Wok de Pollo Supercongelado, marca GREAT VALUE, 400 grs, RNPA: 02-576913 lotes/vto: 188- 17/ 07/07/19, 223-17/ 11/08/19 y 268-17/ 25/09/19.
*Wok de Pollo Supercongelado, marca LA ANONIMA, 400 grs, RNPA: 02-576836 lotes/vto: 181-17/ 10/07/19, 192-17/ 11/07/19 y 249-17/ 06/09/19.
*Wok de Pollo Supercongelado, marca MAGLIA, 400 grs, RNPA: 02-584797 lote/ vto: 263-17/ 20/09/19.
*Wok de Vegetales, marca ERIN, 2500 grs,RNPA: 02-587329 lote/vto: 315-17/ 11/11/19.
*Wok de Vegetales Supercongelados, marca MAGLIA, 400 grs, RNPA N° 02-581376, lotes/vto: 206- 17/ 25/07/19, 304-17/ 31/10/19.
*Wok de Vegetales Supercongelado, marca JUMBO, 400 grs, RNPA N° 2906-2984/15 lotes/vto: 188-17/ 07/07/19 y 319-17/ 15/11/19.
*Wok de Vegetales Supercongelado, marca LA ANONIMA, 400 grs, RNPA N° 2906-2488/15, lotes/vto: 319-17/ 15/11/19, 320-17/ 16/11/19.
*Choclo Supercongelado, marca: CIFSA RNPA: Exp. 4049-28183-2017 Lotes/ Vto.: 55227171 / 15/08/19, W6313G8 / 09/11/18, 55143171/ 23/05/19, 55206171 / 25/07/19, 55208171 / 27/07/19, 55263171 / 20/09/19, 55265171 / 22/09/19, 55276171 / 03/10/19, 55279173 / 06/10/19, 55308171 / 04/11/19, 55314171 / 10/11/19, 55322171 / 18/11/19.
*Ensalada primavera congelada, marca: CIFSA RNPA: 4049-28233-2017 Lotes / Vto: w7897i8 / 11/04/19, 55143171 / 23/05/19, 55160171 / 09/06/19, 55178171 / 27/06/19, 55179171 / 28/06/19, 55143171 / 23/05/19, 55181171 / 30/06/19.
*Arvejas supercongeladas, marca: CIFSA RNPA: 4049-28233-2017 Lote/ Vto.: 55026181/ 26/01/20, 55074181/ 15/03/20, 55143171 / 23/05/19, 55149181 / 29/05/20, 55275171 / 02/10/19, 55326171/ 22/11/19.





















Compartinos tu opinión